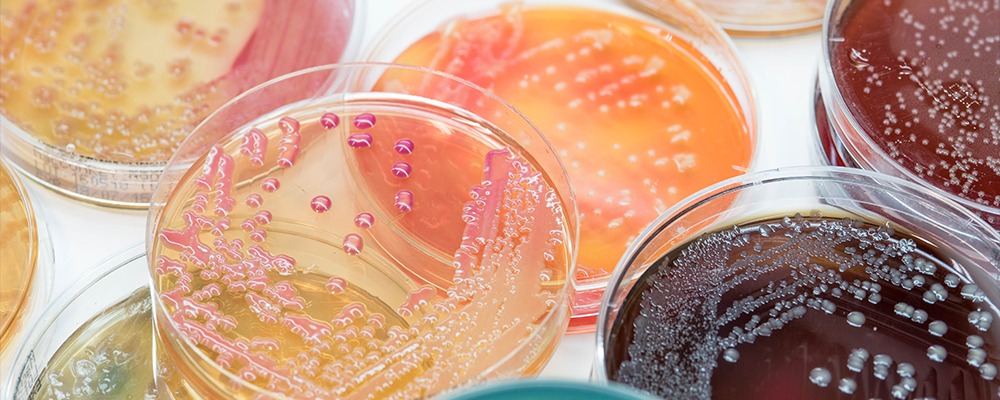
Read more about the article Custom Enzyme Blends: Tailoring Solutions for Industrial Challenges

The Role of Enzymatic Catalysis in Reducing Pharmaceutical Waste
Pharmaceutical manufacturing is under growing pressure to reconcile high production demands with responsible environmental practices. As regulatory bodies, global customers and internal sustainability teams push for cleaner operations, pharmaceutical waste…